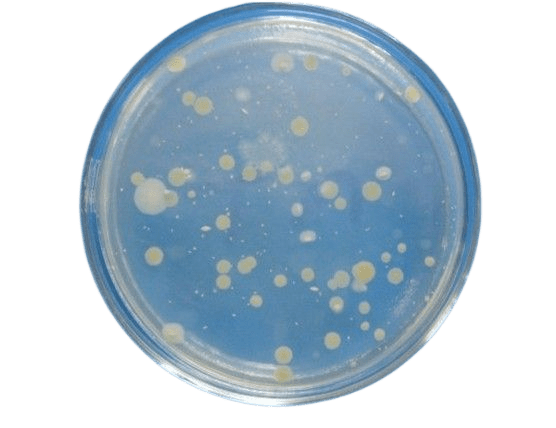
菌落总数的测定!不看你就out啦!_样品_食品论坛_培养基

蓝色菌落

培养皿上的蓝色细菌菌落,照片
图片尺寸300x300
致病性病毒菌落
图片尺寸864x1200
天蓝色链霉菌
图片尺寸250x300
的霉菌限制了原有葡萄球菌的生长,"葡萄球菌菌落变得透明并且被溶解"
图片尺寸900x661
大肠埃希氏菌蓝色菌落鼠伤寒沙门氏菌无色菌落福氏志贺氏菌无色菌落产
图片尺寸544x544
菌落总数非食品安全指标致病菌污染物危害最大
图片尺寸1000x1000
乳酸菌菌落现实
图片尺寸1100x1100
「隔夜西瓜细菌过亿,千万不能吃」,真有这么吓人吗?_菌落
图片尺寸734x494
霉菌美丽,菌落特性的培养培养基板从实验室微生物.
图片尺寸1200x800
复苏质量记录:根据活化要求进行活化,并划线观察单菌落,记录结果如下
图片尺寸365x218
烟曲霉的菌落
图片尺寸220x151
这样的菌落如何计数
图片尺寸1480x1360
菌落总数的测定!不看你就out啦!_样品_食品论坛_培养基
图片尺寸556x428
菌落检测
图片尺寸1280x960
土壤样品琼脂平板上细菌和霉菌的特性及不同形态菌落背景,供微生物学
图片尺寸1200x800
真菌显微形态观察和微生物菌落形态比较
图片尺寸1080x810
今日识菌军团菌
图片尺寸605x562
三天后对比显示,立着餐具的菌落总数为8000cfu/套,符合我国相关卫生
图片尺寸1024x724
吃药不见效?可能是肠道菌落在作怪,这些食物也要注意
图片尺寸640x427
不同颜色的菌落生长在琼脂平板上.
图片尺寸1200x795